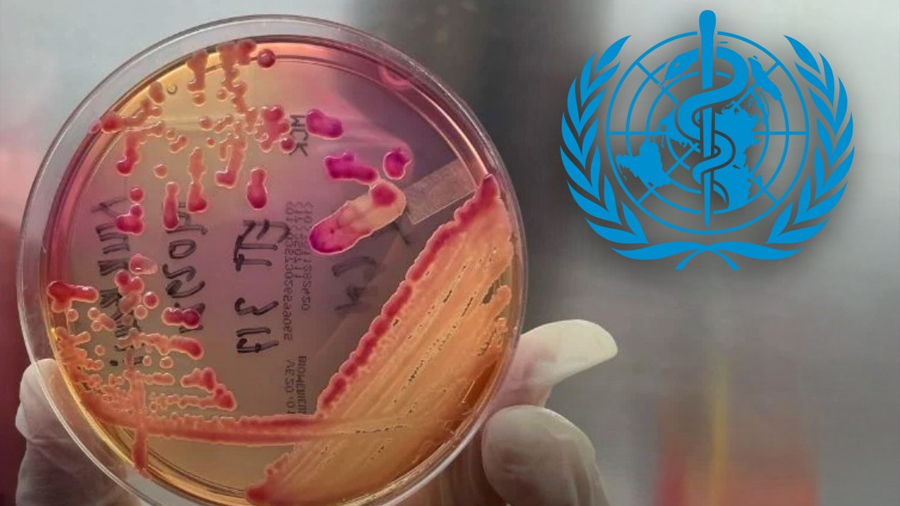

La OMS advierte que la resistencia a los antibióticos crece en todo el mundo y amenaza con convertirse en una crisis sanitaria global
El uso inadecuado de antibióticos está provocando que cada vez más bacterias desarrollen resistencia a los tratamientos, advirtió la Organización Mundial de la Salud (OMS). Según el sistema de vigilancia GLASS, una de cada seis infecciones analizadas en el mundo ya muestra resistencia a los antibióticos.
Alarma mundial por la resistencia bacteriana
La situación es crítica en regiones como África, donde una de cada cinco infecciones es resistente, y en Asia u Oriente Medio, donde la proporción aumenta a una de cada tres. El estudio analizó 22 antibióticos comunes utilizados para tratar infecciones urinarias, gastrointestinales, sanguíneas y de transmisión sexual.
Entre las bacterias más resistentes destacan la E.coli y la Klebsiella pneumoniae, dos de los patógenos más peligrosos por su alta capacidad de causar infecciones graves. Más del 40 % de las cepas de E.coli y un 55 % de K.pneumoniae mostraron resistencia a cefalosporinas de tercera generación, uno de los tratamientos más usados.
“El problema avanza más rápido que la medicina moderna”, advirtió Tedros Adhanom Ghebreyesus, director general de la OMS. Esta resistencia antimicrobiana ya influye en casi 5 millones de muertes anuales y es causa directa de 1.27 millones.
Urge reducir el mal uso de antibióticos
El director del Departamento de Resistencia Antimicrobiana de la OMS, Yvan Hutin, recordó que los antibióticos no deben usarse ante cualquier infección. “Tener fiebre no siempre significa que se necesite un antibiótico”, señaló.
La OMS también subrayó la importancia de la vacunación, la higiene y el lavado frecuente de manos como medidas preventivas. Aunque más países se suman al monitoreo —104 en 2025 frente a 25 en 2016—, los recortes presupuestales y el cierre del Fleming Fund limitan la respuesta ante una amenaza que podría convertirse en la próxima gran crisis sanitaria global.
Fuente: laverdadnoticias.com